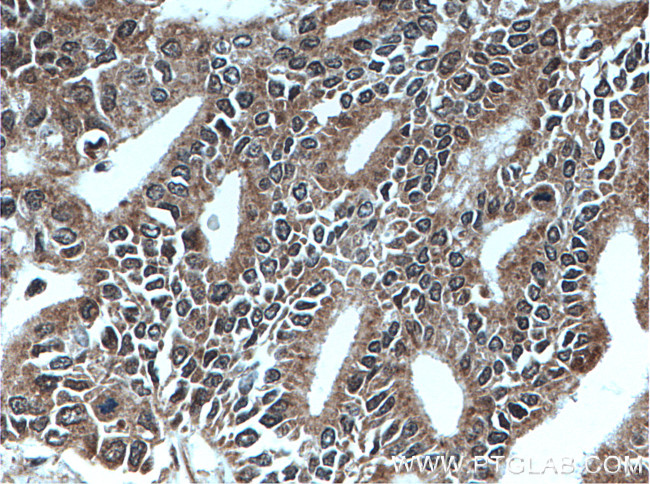
MEST Antibody in Immunohistochemistry (Paraffin) (IHC (P))

Search
Proteintech
MEST Polyclonal Antibody
{{$productOrderCtrl.translations['antibody.pdp.commerceCard.promotion.promotions']}}
{{$productOrderCtrl.translations['antibody.pdp.commerceCard.promotion.viewpromo']}}
{{$productOrderCtrl.translations['antibody.pdp.commerceCard.promotion.promocode']}}: {{promo.promoCode}} {{promo.promoTitle}} {{promo.promoDescription}}. {{$productOrderCtrl.translations['antibody.pdp.commerceCard.promotion.learnmore']}}
产品信息
11118-1-AP
种属反应
已发表种属
宿主/亚型
分类
类型
抗原
偶联物
形式
浓度
规格
纯化类型
保存液
内含物
保存条件
运输条件
产品详细信息
Immunogen sequence: MVRRDRLRR MREWWVQVGL LAVPLLAAYL HIPPPQLSPA LHSWKSSGKF FTYKGLRIFY QDSVGVVGSP EIVVLLHGFP TSSYDWYKIW EGLTLRFHRV IALDFLGFGF SDKPRPHHYS IFEQASIVEA LLRHLGLQNR RINLLSHDYG DIVAQELLYR YKQNRSGRLT IKSLCLSNGG IFPETHRPLL LQKLLKDGGV LSPILTRLMN FFVFSRGLTP VFGPYTRPSE SELWD (1-234 aa encoded by BC011908)
靶标信息
This gene encodes a member of the alpha/beta hydrolase superfamily. It is imprinted, exhibiting preferential expression from the paternal allele in fetal tissues, and isoform-specific imprinting in lymphocytes. The loss of imprinting of this gene has been linked to certain types of cancer and may be due to promotor switching. The encoded protein may play a role in development. Alternatively spliced transcript variants encoding multiple isoforms have been identified for this gene. Pseudogenes of this gene are located on the short arm of chromosomes 3 and 4, and the long arm of chromosomes 6 and 15.
仅用于科研。不用于诊断过程。未经明确授权不得转售。
生物信息学
蛋白别名: DKFZp686L18234; mesoderm specific transcript homolog; Mesoderm-specific transcript homolog protein; Mesoderm-specific transcript protein; MEST; MGC111102; MGC8703; Paternally-expressed gene 1 protein; PEG1/MEST; unnamed protein product
基因别名: 121a; AA408879; AI256745; MEST; PEG1
UniProt ID: (Human) Q5EB52, (Rat) Q6P5P5, (Mouse) Q07646
Entrez Gene ID: (Human) 4232, (Rat) 58827, (Mouse) 17294